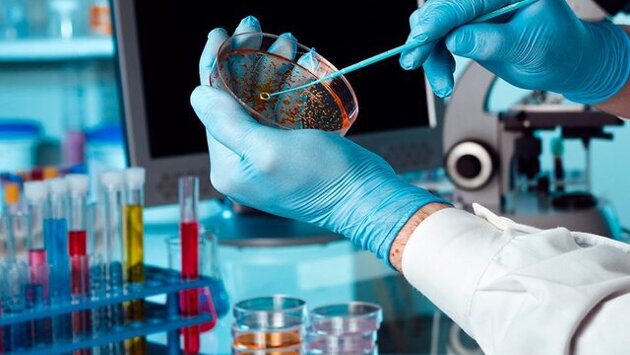

Описанные в СМИ проявления якобы нового вируса соответствуют симптомам ОРВИ, сообщил главный внештатный специалист Минздрава России по инфекционным болезням Владимир Чуланов.
"Новые вирусы или вирусы со значимыми мутациями не выявлены", – заявил он в беседе с ТАСС, сославшись на данные постоянного эпидемиологического мониторинга НИИ гриппа имени А. А. Смородинцева.
Проявления болезни являются симптомами острого респираторного заболевания, возможны бронхит или пневмония, которые могло вызвать большое количество возбудителей, циркулирующих в период эпидемического подъема, считает Чуланов.
Ранее в ряде телеграм-каналов появилась информация о якобы неизвестном вирусе, который вызывает высокую температуру и кашель с кровью, при этом тесты на коронавирус и грипп у больных отрицательные.
В Роспотребнадзоре взяли эту информацию на контроль. Позже специалисты ведомства предположили, что "неизвестный вирус" может быть микоплазменной инфекцией.